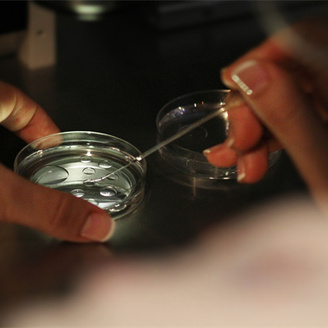
泰国试管婴儿医院大全排名最新：六家优选助孕医院榜单一览

泰国曼谷试管婴儿费用大约多少?机票及住宿翻译费用详细费用分享!
泰国曼谷以其先进的医疗技术和相对合理的价格,成为全球众多家庭选择进行试管婴儿治疗的目的地。对于许多家庭来说,了解试管婴儿的整体费用以及相关的机票、住宿和翻译费用是至关重要的。

男性备孕:北京大学第三医院精子检查费用及医保报销解析
在备孕过程中,男性的精子质量和健康状况同样重要。为了确保精子的质量和数量,许多夫妇选择前往专业医院进行精子检查。北京大学第三医院(简称北医三院)作为国内知名的医疗机构,其生殖医学中心男科提供了全面的精子检查服务。

郑州大学第一附属医院人工授精检查项目及费用详解
在河南省,郑州大学第一附属医院(简称郑大一附院)作为一所集医疗、教学、科研、预防、保健、康复为一体的大型综合性医院,其生殖医学中心在辅助生殖技术方面拥有较高的声誉和丰富的经验。对于希望通过人工授精技术实现生育的家庭来说,了解郑大一附院的相关检查项目及费用是尤为重要的。

子宫内膜炎症是什么原因引起的?患有子宫内膜炎症会影响生育吗?
子宫内膜炎是一种常见的妇科疾病,指子宫内膜发生的炎症反应,通常由细菌感染引起。它不仅会对女性的生殖健康产生多方面的影响,还可能直接影响生育能力。

济南市看不孕不育哪家医院比较好?2025济南不孕不育医院前十强
在现实生活中,生育困境作为现代夫妇的普遍难题,不孕不育问题在其中占据了不可忽视的地位,此时需选择一家合适的医院进行治疗至关重要。济南作为山东省的省会城市,拥有众多专业的不孕不育医院。

泰国试管婴儿费用解析:赴泰试管生子一般需花费多少?
泰国试管婴儿技术的崛起为不孕不育夫妇带来了新的希望和机遇。而泰国,以其优质的服务、相对合理的费用以及宽松的法律法规,成为了许多家庭进行试管婴儿的首选目的地。

广州好的试管婴儿医院有哪些?最新十大试管医院揭晓
当自然受孕的希望破灭,许多夫妻需要携手共度这段艰难时光,这不仅是对他们爱情的一次重大考验,也让整个家庭在困境中学会成长与坚强。而随着辅助生殖技术的不断发展,广州的试管婴儿医院在技术和服务方面均取得了显著进步。

一文解读!齐齐哈尔市第一医院试管婴儿过程详解及费用
试管婴儿技术如同一道闪耀的光芒,为渴望拥有孩子的夫妇指引了方向,助力他们跨越了生育的难关,实现了家庭梦想的愿望。黑龙江省齐齐哈尔市第一医院作为该地区知名的医疗机构,在试管婴儿领域拥有丰富的经验和先进的技术。

做试管婴儿的促排卵药物选国内的好?还是选国外促排药物好?
试管婴儿技术凭借其非凡的力量,成为了解决不孕不育问题的璀璨明珠,为渴望成为父母的夫妇铺就了一条通往幸福家庭的道路。在这一复杂而精细的过程中,促排卵药物起到了至关重要的作用。

北京试管婴儿生殖学科专家排名榜:十位靠谱医生推荐
北京作为中国的医疗中心,汇聚了众多优质的医疗资源,特别是在试管婴儿技术方面,拥有众多经验丰富、技术精湛的专家。以下是十位在北京地区备受认可的试管婴儿生殖学科专家,他们凭借丰富的临床经验和卓越的专业技能,为无数家庭带来了生育的希望。

试管知识:试管移植囊胚的成功率有多高?看看专家怎么说?
试管婴儿技术就像一束希望的曙光,穿透了漫长等待的黑暗,点亮了无数渴望成为父母的夫妇心中的希望之火。其中试管移植囊胚作为现代辅助生殖技术的重要组成部分,帮助许多不孕不育的夫妇实现了生育梦想。

大龄女性备孕:AMH 0.34,还能自然怀孕吗?试管是选择吗?
随着现代生活节奏的加快和生育观念的改变,越来越多的女性选择在较晚的年龄进行备孕。但随着年龄的增长,女性的生育能力会逐渐下降,卵巢功能的评估变得尤为重要。其中,AMH(抗缪勒管激素)是一项重要的检测指标,用于评估卵巢储备功能和预测女性生育能力。

做试管婴儿多次促排卵会加速女性老化吗?专家回复来了!
在生殖科学领域的不断探索中,试管婴儿技术借助科技的飞速提升,已化作破解生育难题的神奇钥匙。对于众多渴望拥有孩子的夫妇而言,这一技术不仅是医学研究的一项重大成果,更是他们通往梦想家庭的大门。面对这项技术的广泛应用,一个备受关注的问题逐渐浮出水面:多次促排卵是否会加速女性的老化过程?

国内试管婴儿第三代技术哪里做得好?哪家医院成功率高于60%?
对于渴望生育的家庭来说,选择一家合适的试管婴儿医院是至关重要的一步,因为这直接关系到治疗的成效、患者的心理健康及家庭的长远发展与幸福。随着技术的不断进步,第三代试管婴儿技术(PGD/PGS)更是以其高效、安全的特点,成为解决不孕不育问题的优选方法。

城市
医院
医生